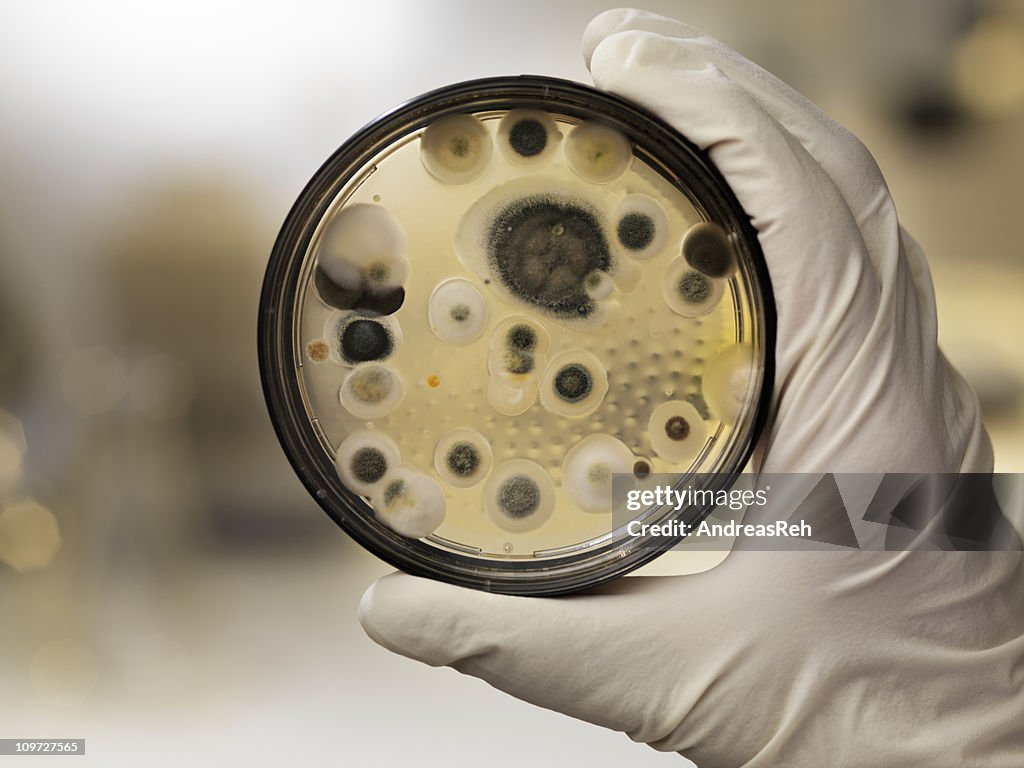
Mehltau Kultur auf agar Teller, Labor Motiv

Mehltau Kultur auf agar Teller, Labor Motiv - Stock-Fotografie

Sichern Sie sich dieses Bild in einem von vielen Rahmen auf Photos.com.
EINE LIZENZ KAUFEN
Alle Lizenzen für lizenzfreie Inhalte beinhalten weltweite Nutzungsrechte, umfangreichen Schutz und eine einfache Preisgestaltung mit Mengenrabatten
335,00 €
EUR
Getty ImagesMehltau Kultur Auf Agar Teller Labor Motiv, Stock-Foto Laden Sie authentische Premium-Fotos zum Thema Mehltau Kultur auf agar Teller, Labor Motiv von Getty Images herunter. Entdecken Sie ähnliche hochauflösende Fotos in unserem umfangreichen Bildkatalog.Product #:109727565
Laden Sie authentische Premium-Fotos zum Thema Mehltau Kultur auf agar Teller, Labor Motiv von Getty Images herunter. Entdecken Sie ähnliche hochauflösende Fotos in unserem umfangreichen Bildkatalog.Product #:109727565
Laden Sie authentische Premium-Fotos zum Thema Mehltau Kultur auf agar Teller, Labor Motiv von Getty Images herunter. Entdecken Sie ähnliche hochauflösende Fotos in unserem umfangreichen Bildkatalog.Product #:109727565
Laden Sie authentische Premium-Fotos zum Thema Mehltau Kultur auf agar Teller, Labor Motiv von Getty Images herunter. Entdecken Sie ähnliche hochauflösende Fotos in unserem umfangreichen Bildkatalog.Product #:109727565335€50€
Getty Images
In stockDETAILS
Bildnachweis:
Creative #:
109727565
Lizenztyp:
Kollektion:
E+
Max. Dateigröße:
7216 x 5412 px (61,10 x 45,82 cm) - 300 dpi - 12 MB
Hochgeladen am:
Releaseangaben:
Keine Freigaben erforderlich
Kategorien:
- Schimmel - Pilz,
- Penicillin - Pilz,
- Grüner Schimmel,
- Petrischale,
- Schwarzschimmel,
- Giftstoff,
- Mehltau,
- Gesundheitswesen und Medizin,
- Labor,
- Cladosporium,
- Agargel,
- Mikrobiologie,
- Wissenschaft,
- Analysieren,
- Biologie,
- Biotechnologie,
- Eine Person,
- Farbbild,
- Fokus auf den Vordergrund,
- Forschung,
- Fotografie,
- Halten,
- Horizontal,
- Hygiene,
- Laborglas,
- Menschen,
- Menschliche Hand,
- Menschliches Körperteil,
- Schimmelpilzgift,
- Schutzhandschuh,
- Toxikologie,
- Variable Schärfentiefe,